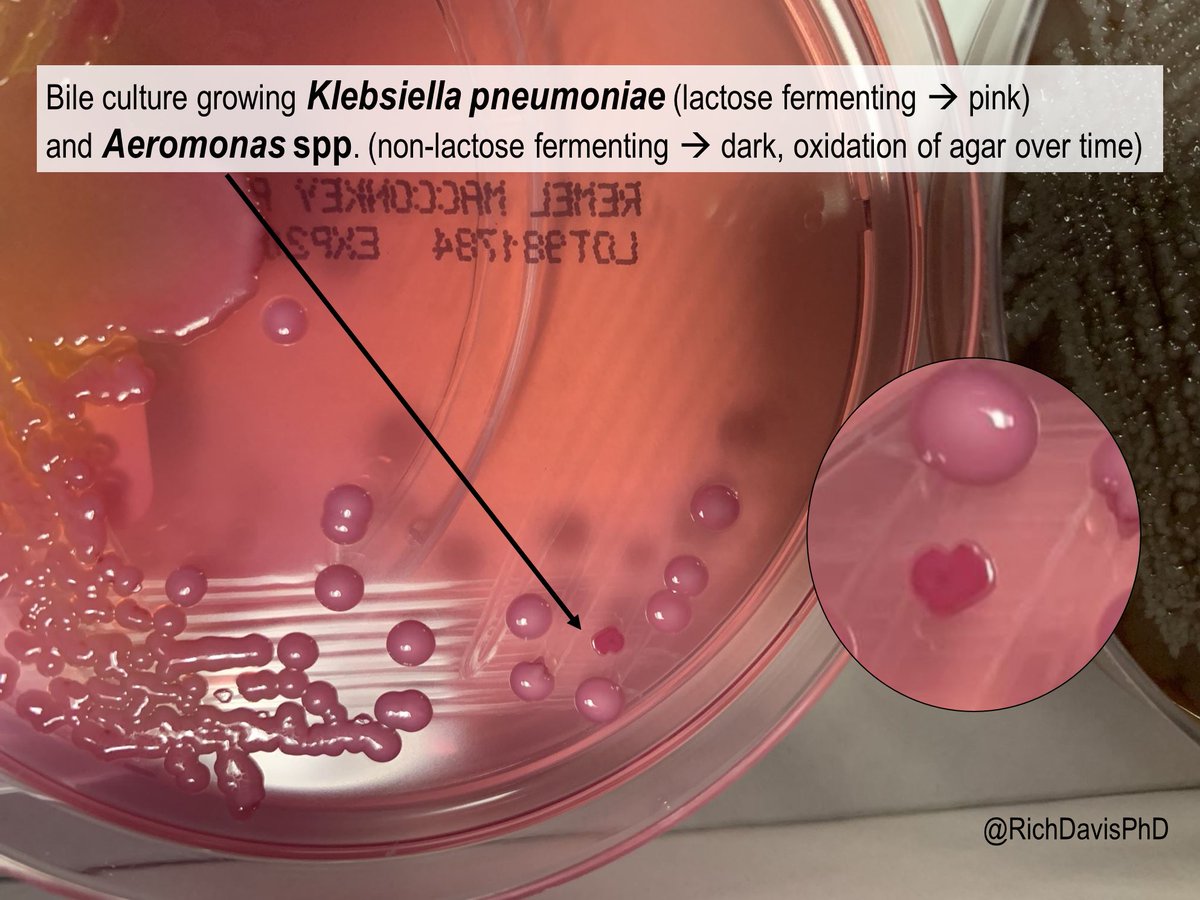
richdavisphd's tweet image. #MicroRounds (Day 974): &quot;Keeping you on your (lac)toes&quot;

Fermentation of lactose in MacConkey agar helps to ID Gram negatives. This bile culture shows a lactose fermenting K. pneumoniae plus a non-fermenting Aeromonas (the *dark* pink color is oxidation) #ASMClinMicro #IDTwitter

Ideal
@soo_ideal
God’s own ||Biomedical science||🧪 🧫 🥼|| Msc BMLS|| IG @soo_ideal , TikTok @soo_idealy
You might like
God did it and I made it. A big DISTINCTION in MSc Biomedical Laboratory science. All I can say is WHAT GOD CANNOT DO DOES NOT EXIST. This is one of the hardest journeys I have had to embark on with no idea of how I will scale through, but I finished and finished even strong💪🏿




Am I the only one that have songasm? Like anytime I’m playing the song I like, my body will be sweeting me 😂😂🤭🤭
These ones are the real odogwus, “mummy give me your watsup numba” 😂😂
Another year to thank the Lord for💃🏼🎉😊 Happy birthday to me.



Mucor cirinelloides isolatd 4rm simulatd sinus content 4rm a diabetic patient with sinus pain & headache.They can cause opportunistic disease in imunocompromisd individuals e.g diabetic patients.Mucor spp.are differentiatd 4rm Rhizopus or Rhizomucor spp based on lack of rhizoids



#MicroRounds (Day 974): "Keeping you on your (lac)toes" Fermentation of lactose in MacConkey agar helps to ID Gram negatives. This bile culture shows a lactose fermenting K. pneumoniae plus a non-fermenting Aeromonas (the *dark* pink color is oxidation) #ASMClinMicro #IDTwitter
Why are you using antibiotics to treat a viral infection? 😠😠😠 You people are the ones causing this antimicrobial resistance superbug.🤦🏽♀️🤦🏽♀️
What does a mask do? Blocks respiratory droplets coming from your mouth and throat. Two simple demos: First, I sneezed, sang, talked & coughed toward an agar culture plate with or without a mask. Bacteria colonies show where droplets landed. A mask blocks virtually all of them.


It’s my birthday today & a new chapter in my life. This birthday is special to me☺️🫠. This is definitely the season I will flourish. Say a prayer for me guys🕺🏻🤸🏽♀️🎂🥳 #26thjune #HappyBirthday #thankyoulord




An idiots guide to chickenpox 🐔 + shingles + VZV. A short 🧵 containing essential bits of basic info to help you understand this highly contagious and extremely common infection/disease.

United States Trends
- 1. Happy Thanksgiving 218K posts
- 2. #StrangerThings5 316K posts
- 3. Afghan 356K posts
- 4. #DareYouToDeath 199K posts
- 5. BYERS 73.3K posts
- 6. DYTD TRAILER 137K posts
- 7. robin 110K posts
- 8. Turkey Day 14.8K posts
- 9. Good Thursday 21.1K posts
- 10. Dustin 57.4K posts
- 11. Vecna 73.3K posts
- 12. Feliz Día de Acción de Gracias N/A
- 13. Taliban 46K posts
- 14. Reed Sheppard 7,501 posts
- 15. Holly 73.9K posts
- 16. Rahmanullah Lakanwal 139K posts
- 17. Jonathan 76.3K posts
- 18. Nancy 71.6K posts
- 19. noah schnapp 9,667 posts
- 20. Tini 11.8K posts
You might like
-
 TheLens24
TheLens24
@SirChely -
 MedLabConvo
MedLabConvo
@Medlabconvo -
 JCO
JCO
@jcomls -
 The fit girl
The fit girl
@PreciousAnene1 -
 MLSCN
MLSCN
@MedLabNigeria -
 spitting replica of PROGRESS
spitting replica of PROGRESS
@ShadrackAsamota -
 Repro Scientist
Repro Scientist
@ShololaDamilol2 -
 Sharrun Osarobo
Sharrun Osarobo
@Sharrun10 -
 designDev();
designDev();
@Sammysplendor -
 YMLSF Rivers State
YMLSF Rivers State
@YMLSF_Rivers -
 Wonderful Ifeanyichukwu Anowai
Wonderful Ifeanyichukwu Anowai
@manWNDRFL -
 Bella 🌷Fidelam homes Abuja 🏡
Bella 🌷Fidelam homes Abuja 🏡
@LyndaZax -
 Favour Nnadi, MBA.
Favour Nnadi, MBA.
@DigitalFav_our -
 Esumeh Collins
Esumeh Collins
@CollinsEsumeh -
 👷Francis Nwaiwu🎅
👷Francis Nwaiwu🎅
@nwaiwu_francis
Something went wrong.
Something went wrong.






















































































































